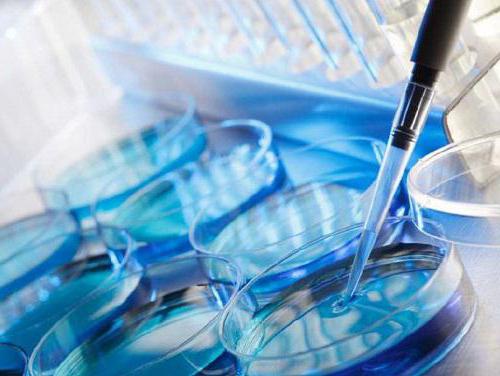
how can i get an eco quota

It’s not easy to get pregnant. Especially today, when many couples are recognized as barren. Nevertheless, there is a way out. We will tell you how to achieve your desired goal. Reproductive assistive technologies include intracellular (intracytoplasmic) sperm implantation (ICSI) and IVF (in vitro fertilization). These events are considered ultramodern types of medical assistance, which are free for citizens of the Russian Federation. The process of providing this medical care is regulated by certain regulatory and legislative documents.
Infertility treatment using such technologies is an expensive medical service. There is a widespread misconception in society related to the provision of quotas for a free in vitro fertilization session, which states that it is almost impossible to obtain such a document. In this article, we will provide the opposite information and relieve you of uncertainty.
How to get a quota for a mandatory medical insurance policy
Let's find out how to get a quota for IVF by compulsory medical insurance. Today, many families are faced with the need for this operation. However, an enormous amount of money must be paid for IVF. Meanwhile, for some couples it is the only means of giving birth to the desired children. At present, birth rates in Russia have declined, therefore quotas have been provided to allow the operation to be performed for free.

With the help of innovative methods, today you can give birth to a healthy child, even having any disease. Back in 2013, quotas for IVF appeared on compulsory medical insurance. Since that time, about 5 million children were born in Russia.
When IVF is needed
So, we continue to figure out how to get a quota for IVF. In order for doctors to allow this operation, a person must have the following diseases:
- male infertility;
- infertility in both spouses;
- absolute obstruction of the fallopian tubes;
- endocrine diseases;
- infertility for unknown reasons;
- negative effect after removal of the fallopian tubes;
- immunological diseases;
- lack of result of surgery or conservative treatment.
Quotas
Little is known how to get an IVF quota. Since 2013, a number of regions of the Russian Federation have been conducting their own IVF program. It is funded from the local budget. In these regions, the line is moving much faster, in addition, each participant in this program has the right to undergo IVF twice for free. Among these regions:
- Moscow and Moscow region;
- St. Petersburg;
- Novosibirsk
- Omsk
- Irkutsk and others
To find out if such programs exist in your area, you need to contact the territorial MHIF.

The cost of the procedure is paid by the Health Insurance Fund. The document governing the provision of this assistance is valid from January 1, 2015. For each experiment, the state allocates 106,000 rubles. If the cost of the procedure exceeds this amount, you will have to pay extra on your own.
How to get a quota for IVF? This question is of interest to those who cannot conceive naturally. The number of quotas is approved annually. In 2015, this number was about 700 cycles. The wait can last from 2 to 12 months and depends on the number of quotas approved in a particular region.

MHI program
What is included in the compulsory medical insurance policy on compulsory fertilization? The client will need to perform the following steps:
- stimulate the ovaries;
- perform a puncture;
- grow an embryo;
- carry out IVF procedure.
Of course, in the event that donor materials or additional therapy are required, a couple will have to pay for them.
Right to choose
Quite recently, the question of how to get a quota for IVF in Moscow worried many. And in what situations is the need for this operation? From a medical point of view, spouses with regular relationships are considered infertile when they have no children. Therefore, they are first sent to a hospital for treatment. If there is no result after undergoing therapy, then the question arises of the implementation of IVF.
Before the event, the couple needs to undergo a thorough examination. Husband and wife should check the hormonal background, do an ultrasound scan, take different tests, a spermogram and find out the presence of infectious diseases.
So, we learned how to get an IVF quota. But we continue our story. After the couple was handed the referral, she gets the right to choose the appropriate hospital, where artificial insemination will be carried out according to the policy. Previously, not all spouses could exercise this right. Today there is a list of medical institutions that participate in the compulsory medical insurance program.
You can choose a good clinic in Moscow or another Russian city. Many hospitals have high-class specialists who provide quality services. Therefore, those who own MHI policies can give birth to a healthy baby for free. Thanks to the decision of the authorities, it is no longer necessary to ask how to get a quota for free IVF.
Participation
In accordance with the terms of the federal project, not only married couples, but also single women, and those who are married together, can take part in it. To do this, follow these steps:
- See a doctor for a consultation. He will send you to be examined and treated. If the result is zero, the doctor will diagnose infertility. Then he will give you an IVF referral.
- Now, having collected some documents, it is necessary to stand in line. Next, they will provide you with a quota under the VIP or OMS.
Preparation of documents
Where to get a quota for IVF? To get a referral for a quota, you need to contact a antenatal clinic or other health facility where you are being observed for infertility.
And now we will consider what documents need to be prepared for artificial insemination. Customers must have:
- An extract from the hospital, certified by the doctor who provided the treatment. On this paper should be the seal of the clinic doctor.
- It is necessary to ensure that the code for the ICD-10 and the diagnosis are indicated in the statement.
- Health information for a married couple or patient.
- Analyzes taken at the hospital.
- Photocopy of a civil passport.
- SNILS.
- A photocopy of the compulsory medical insurance, if any.
- You must confirm your consent to the verification of data.
After that, all the information is transferred to the hospital, which is in the register of institutions included in the VMP and compulsory medical insurance. Lists are formed on a special website on the Web in accordance with the queue.

Further, the commission considers the documents and makes a decision on IVF within 10 days. If the answer is yes, then a special protocol is drawn up in the form prescribed by law.
Attempts
Many do not know how many times you can get a quota for IVF. In the European Union, for example, at the expense of social insurance funds in France, 4 IVF attempts are provided, in the Netherlands - three, in Greece - three, in Austria - four. In Russia, there is no limit on the number of experiments with artificial insemination established by law. People have the right to submit documents for the operation countless times.

Nevertheless, practice shows that infertile spouses can make only two attempts a year. After all, a waiting list is rarely rare. Some wait months and even years.Of course, this question is purely individual.
Test List

What actions need to be performed in order to get a referral to free IVF? The permanent list of analyzes includes the following procedures:
- Endometrial biopsy.
- Hemostasiogram.
- A snapshot of the fallopian tubes and uterus to be taken in the middle of the menstrual cycle.
- A smear on the flora.
- Blood test for inclusion of antiphospholipid antibodies.
- Ultrasound examination of the mammary and thyroid glands, abdominal organs.
- Analysis for toxoplasmosis and rubella.
- Biochemical and general blood tests.
- A blood test to determine the hormonal status of the patient (testosterone, cortisol, progesterone, prolactin and others).
- A smear from the cervix (this analysis is considered valid for one year).
- Electrocardiogram.
- The written opinion of the doctor-therapist that the woman has no contraindications for IVF and subsequent pregnancy.
- Blood on CMV.
- Urinalysis (general).
And the man needs to perform the following actions:
- Pass a spermogram.
- Go through a detailed consultation with an andrologist-urologist.
- Screened for sexually transmitted infections.
Also, both partners must undergo such studies:
- Examine blood for the presence of syphilis (RW), hepatitis B and C, HIV.
- Take tests to determine the blood group and Rh factor.
- Consult a geneticist and, if necessary, be examined for a predisposition to genetic abnormalities.
In addition to analyzes, papers concerning the legal side of the issue should be submitted to the medical commission.
When making a decision, members of the medical commission primarily pay attention to the presence or absence of indications for IVF. That is why all documentation must be accurately and correctly executed.



